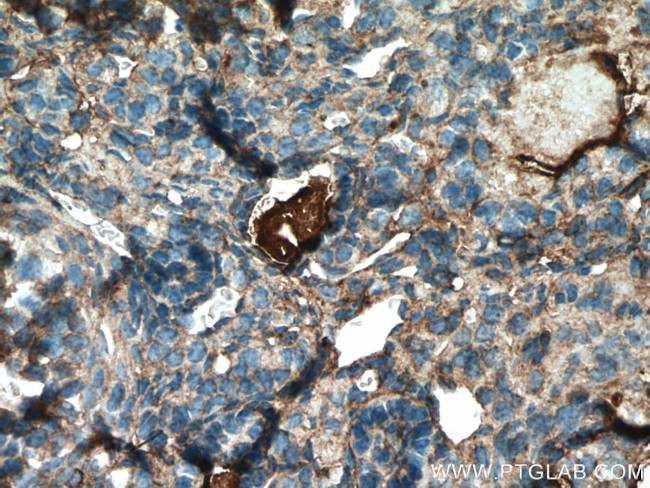
AANAT Antibody in Immunohistochemistry (Paraffin) (IHC (P))

Search
Proteintech
AANAT Polyclonal Antibody
{{$productOrderCtrl.translations['antibody.pdp.commerceCard.promotion.promotions']}}
{{$productOrderCtrl.translations['antibody.pdp.commerceCard.promotion.viewpromo']}}
{{$productOrderCtrl.translations['antibody.pdp.commerceCard.promotion.promocode']}}: {{promo.promoCode}} {{promo.promoTitle}} {{promo.promoDescription}}. {{$productOrderCtrl.translations['antibody.pdp.commerceCard.promotion.learnmore']}}
产品信息
17990-1-AP
种属反应
已发表种属
宿主/亚型
分类
类型
抗原
偶联物
形式
浓度
规格
纯化类型
保存液
内含物
保存条件
运输条件
产品详细信息
Immunogen sequence: MSTQSTHPL KPEAPRLPPG IPESPSCQRR HTLPASEFRC LTPEDAVSAF EIEREAFISV LGVCPLYLDE IRHFLTLCPE LSLGWFEEGC LVAFIIGSLW DKERLMQESL TLHRSGGHIA HLHVLAVHRA FRQQGRGPIL LWRYLHHLGS QPAVRRAALM CEDALVPFYE RFSFHAVGPC AITVGSLTFM ELHCSLRGHP FLRRNSGC (1-207 aa encoded by BC092430)
靶标信息
Arylalkylamine N-Acetyltransferase (AANAT) is the penultimate enzyme is melatonin synthesis. Hormonal melatonin has been implicated in sleep and circadian clock function. Large changes in the abundance of AANAT are believed to be responsible for the large day/night rhythms in melatonin synthesis in the pineal gland and retina. Most research shows that AANAT activity is regulated by controlling the steady-state levels of the protein. Recent research, however, suggests that another mechanism may also play a role in controlling melatonin production without altering AANAT protein and activity. This mechanism may explain the sudden physiological increase in circulating melatonin observed at the onset of the dark period in humans.
仅用于科研。不用于诊断过程。未经明确授权不得转售。
生物信息学
蛋白别名: AA-NAT; Aralkylamine N-acetyltransferase; arylakylamine N-acetyltransferase; Arylalkylamine N - acetyltransferase (Serotonin N - acetyltransferase); arylalkylamine N-acetyltransferase; Seretonin N-acetyltransferase; Serotonin acetylase; Serotonin N-acetyltransferase
基因别名: AA-NAT; AANAT; DSPS; Nat-2; Nat4; SNAT
UniProt ID: (Human) Q16613, (Mouse) O88816, (Rat) Q64666
Entrez Gene ID: (Human) 15, (Mouse) 11298, (Rat) 25120